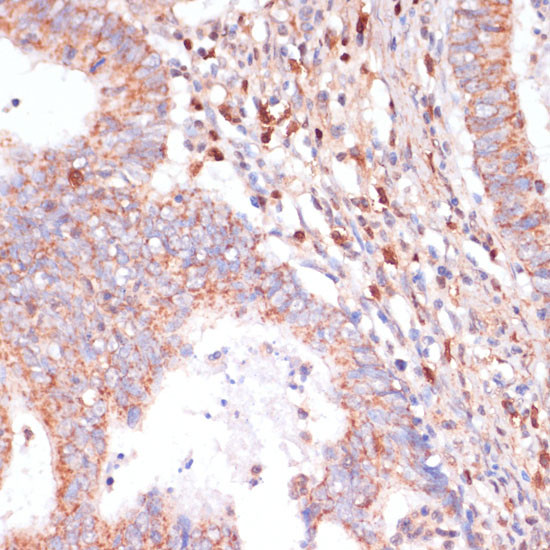
CACNB2 Antibody in Immunohistochemistry (Paraffin) (IHC (P))

Search
Invitrogen
CACNB2 Polyclonal Antibody
{{$productOrderCtrl.translations['antibody.pdp.commerceCard.promotion.promotions']}}
{{$productOrderCtrl.translations['antibody.pdp.commerceCard.promotion.viewpromo']}}
{{$productOrderCtrl.translations['antibody.pdp.commerceCard.promotion.promocode']}}: {{promo.promoCode}} {{promo.promoTitle}} {{promo.promoDescription}}. {{$productOrderCtrl.translations['antibody.pdp.commerceCard.promotion.learnmore']}}
图: 1 / 4
CACNB2 Antibody (PA5-90894) in IHC (P)




Please note: We are reviewing Western blot images included in the antibody testing data in our catalog, including those provided by third parties. Unless expressly labeled or annotated as “raw-unedited”, Western blot images included in the antibody testing data in our catalog may have been edited, optimized or otherwise adjusted for presentation.
产品信息
PA5-90894
种属反应
宿主/亚型
分类
类型
抗原
偶联物
形式
浓度
规格
纯化类型
保存液
内含物
保存条件
运输条件
RRID
产品详细信息
Positive Samples: Mouse heart; Cellular Location: Cell membrane, Cytoplasmic side, Peripheral membrane protein, sarcolemma
靶标信息
The expression of multiple classes of voltage dependent calcium channels (VDCCs) allows neurons to tailor calcium signaling to functionally discrete cellular regions. Although N-Type VDCCs exist before birth which is consistent with a role in migration, most N-Type VDCCs subunit expression is postnatal and is important in the genesis of synaptic transmission in discrete hippocampal fields.
⚠WARNING: This product can expose you to chemicals including mercury, which is known to the State of California to cause birth defects or other reproductive harm. For more information go to www.P65Warnings.ca.gov.
仅用于科研。不用于诊断过程。未经明确授权不得转售。
篇参考文献 (0)
生物信息学
蛋白别名: CAB1; CAB2; CACNLB1; Calcium channel voltage-dependent subunit beta 2; calcium channel, voltage-dependent, beta 2 subunit; CCHLB1; Lambert-Eaton myasthenic syndrome antigen B; MGC138502; MGC138504; MGC41896; myasthenic (Lambert-Eaton) syndrome antigen B; MYSB; unnamed protein product; Voltage-dependent L-type calcium channel subunit beta-2; voltage-gated calcium channel beta2 subunit transcript variant X13
基因别名: AW060387; CAB2; CACNB2; CACNLB2; CAVB2; Cavbeta2; Cchb2; MYSB
UniProt ID: (Mouse) Q8CC27, (Rat) Q8VGC3
Entrez Gene ID: (Human) 783, (Mouse) 12296, (Rat) 116600